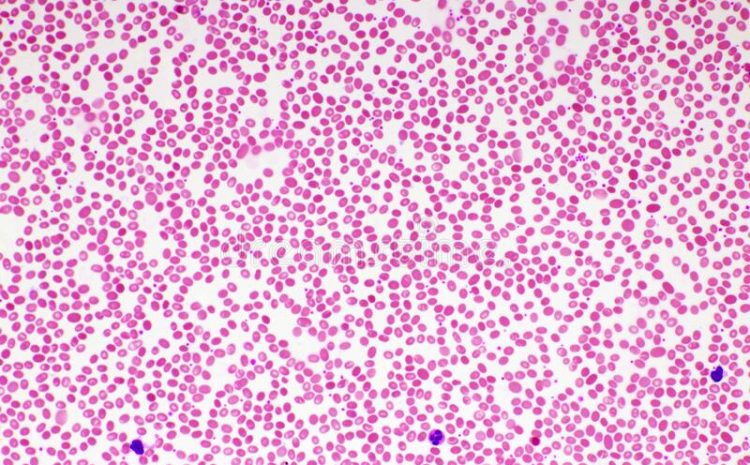

El estudio del frotis sanguíneo es un procedimiento de laboratorio que se utiliza para analizar la morfología de las células sanguíneas. Este examen, también conocido como lámina periférica o extendido de sangre periférica, es una herramienta fundamental en la práctica de la hematología. El objetivo del estudio de lámina periférica es identificar cualquier anomalía en la morfología de los elementos sanguíneos, como los glóbulos rojos, los glóbulos blancos y las plaquetas, que sea de valor diagnóstico y clínico.
En este artículo, exploraremos en detalle el procedimiento del frotis sanguíneo, su importancia en el diagnóstico de diversas enfermedades y algunos aspectos importantes a tener en cuenta al interpretar los resultados.
Procedimiento del frotis sanguíneo
El frotis sanguíneo se realiza a partir de una pequeña muestra de sangre obtenida principalmente mediante punción venosa en el brazo del paciente. La muestra se coloca en un portaobjetos de vidrio limpio y se extiende con un segundo portaobjetos para crear una capa fina y uniforme de células.
A continuación, el frotis se tiñe con colorantes especiales, como el colorante de Wright o el Giemsa, para facilitar la identificación de las diferentes células sanguíneas. Los glóbulos rojos, por ejemplo, adquieren un tono rosa o naranja, mientras que los glóbulos blancos y las plaquetas adquieren tonos azulados o púrpuras a lilas y rosados, según su estructura nuclear y citoplasmática.
Una vez teñido, el frotis se examina al microscopio para observar las características de las células sanguíneas. El examen se realiza en diferentes áreas del frotis para obtener una visión completa de la muestra y detectar cualquier variación en la morfología celular.
Importancia del frotis sanguíneo en el diagnóstico de enfermedades
El frotis sanguíneo es una herramienta fundamental en el diagnóstico de diversas enfermedades hematológicas. Algunos de los trastornos que se pueden detectar mediante esta técnica son:
Anemia: El frotis sanguíneo es útil para identificar las características de los glóbulos rojos, como su tamaño y forma. En la anemia, los glóbulos rojos pueden ser más pequeños de lo normal (microcitos) o tener una forma irregular (poiquilocitosis), lo que indica un defecto estructural y funcional que conlleva una disminución de la capacidad de transporte de oxígeno de la sangre.
Leucemia: La leucemia es un cáncer de los glóbulos blancos que se caracteriza por una proliferación excesiva y anómala de estas células. El frotis sanguíneo puede mostrar la presencia de blastos, células inmaduras que no deberían estar presentes en la sangre periférica de adultos sanos.
Trombocitopenia: La trombocitopenia es un trastorno en el que el número de plaquetas en la sangre es bajo. El frotis sanguíneo puede mostrar plaquetas hipogranulares/agranulares, lo que indica una disminución de la función plaquetaria.
Infecciones virales: Algunas infecciones virales, como la mononucleosis infecciosa, pueden afectar las células sanguíneas.